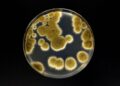
Вчені кажуть, що цей гриб може пережити подорож на Марс
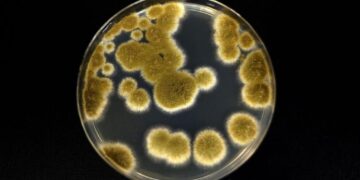
Вчені кажуть, що цей гриб може пережити подорож на Марс

Президент США Дональд Трамп не відмовиться від своїх зусиль, спрямованих на завершення війни в Україні. Про це заявив держсекретар США Марко Рубіо в телефонній розмові з міністром закордонних справ Угорщини Петером Сійярто, передає «Главком».
«Трамп – єдиний лідер, що володіє силою повернути мир у Центральну Європу, і, на відміну від деяких європейських політиків, Угорщина твердо підтримує його місію», –повідомив Сійярто у соцмережі X.
За словами Сійярто, Рубіо запевнив його, що зусилля Трампа будуть тривати. Це, як зазначив угорський міністр, дає «справжню надію на те, що ця руйнівна війна нарешті може закінчитися».
Раніше держсекретар Марко Рубіо зазначив, що розповіді кремлівського диктатора Володимира Путіна про «першопричини війни» в Україні абсолютно нецікаві США. Про це він сказав в інтерв’ю CBS News, передає «Главком».
«Під першопричинами війни він (Путін – «Главком») має на увазі ці довгі історичні скарги, які ми чули багато разів. Це не новий аргумент, він говорить про це давно, і це аргумент про нібито наступ Заходу. Я не хочу про це говорити, це занадто довго. Ми не будемо на цьому зосереджуватися», – сказав Рубіо.
До слова, президент США Дональд Трамп вважає, що завершити російсько-українську війну доволі складно, але він налаштовний оптимістично. Ба більше, він нагадав, що закінчив вже шість воєн та йому подобається їх зупиняти.
Як відомо, 18 серпня у Білому домі відбулась зустріч Трампа та президента Зеленського. Лідери двох країн спочатку спілкуватися в Овальному кабінеті. Політики виголосили вітальні промови та відповідали на питання журналістів. Після цього вони провели вже закриті перемовини.
Згодом президенти США та України провели зустріч з європейськими лідерами. Зокрема, на зустрічі були присутні президентка Європейської комісії Урсула фон дер Ляєн, президент Франції Еммануель Макрон, прем’єр-міністр Великої Британії Кір Стармер, канцлер Німеччини Фрідріх Мерц, прем’єр-міністерка Італії Джорджія Мелоні, президент Фінляндії Александр Стубб та генеральний секретар НАТО Марк Рютте.
Варто зазначити, що 15 серпня на Алясці відбулась зустріч президента Трампа з Путіним. Зустріч Трампа і Путіна, що тривала майже три години, включно з розмовою віч-на-віч у лімузині, закінчилася позитивними заявами обох лідерів про прогрес у переговорах. Однак, угоди щодо України, яка була центральним питанням, досягнуто не було.